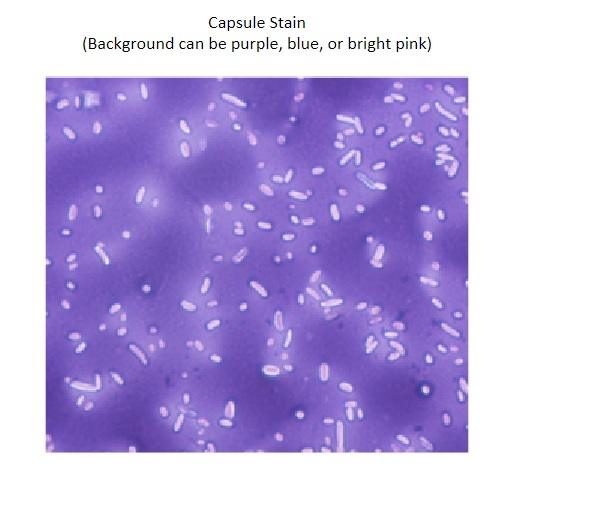

what are the four steps of differential staining?
- primary stain - colors the target cell
- mordant - helps color stick in target cells
- decolorizer - removes color from background and non-target cells
- counterstain - stains non-target cells
what are the four chemicals used for gram stain?
- primary stain: crystal violet
- mordant: iodine
- decolorizer: acetone/alcohol
- counterstain: safranin

what is the primary stain in gram staining?
crystal violet
what is the mordant in gram staining?
iodine
what is the decolorizer used in gram staining?
alcohol and acetone
what is the counterstain used in gram staining?
safranin
what were the target and non-target cells used in gram stain? what color should they have been?
target: Staphylococcus aureus - purple
non-target: Escherichia coli - pink

what are the four chemicals used for acid fast stain?
- primary stain: basic fuchsin
- mordant: phenol + dimethyl sulfoxide
- decolorizer: acid-alcohol
- counterstain: methylene blue

what were the target and non-target cells used in acid fast stain? what color should they have been?
target: Mycobacterium smegmatis - pink
non-target: Staphylococcus aureus - blue

what are the four chemicals used for endospore stain?
- primary stain: malachite green
- mordant: steam
- decolorizer: distilled water
- counterstain: safranin
what were the target and non-target cells used in endospore stain? what color should they have been?
target: endospores - green
non-target: vegetative cells - pink
what is the primary stain in capsule staining?
congo red
what is the purpose of the acid-alcohol for the capsule stain? how is this different than how it was used for acid-fast?
In capsule staining, acid-alcohol chemically fixes the cells to the slide
In acid-fast, acid-alcohol is used as the decolorizer
what is the secondary stain used in capsule staining?
carbol fuchsin
How do capsules appear at the end of capsule staining?
background will be dark blue/purple and magenta
capsules will look like a clear halo around the pinkish color of the bacillus shaped cell
what was the target bacteria in capsule stain? what color?
Klebsiella pneumoniae - mostly colorless
what is the purpose of streak plating?
to produce pure, isolated colonies from a mixed sample
what antibiotic was most and least effective?
Most: Chloramphenicol
Least: Bacitracin
Which bacterial type is the most and least susceptible to antibiotics?
most susceptible: Mycobacterium smegmatis
least susceptible: Escherichia coli
what does the death zone of a susceptible organism look like?
large death zone
what does the death zone of a resistant organism look like?
small/no death zone
what antiseptic was most and least effective?
Most effective – 1% formaldehyde
Least effective – 70% isopropyl alcohol
which bacterial type is the most and least susceptible to antiseptics?
most susceptible: Mycobacterium smegmatis
least susceptible: Escherichia coli
what is the equation to convert Celsius to Fahrenheit
°F = (°C x 1.8) + 32




































